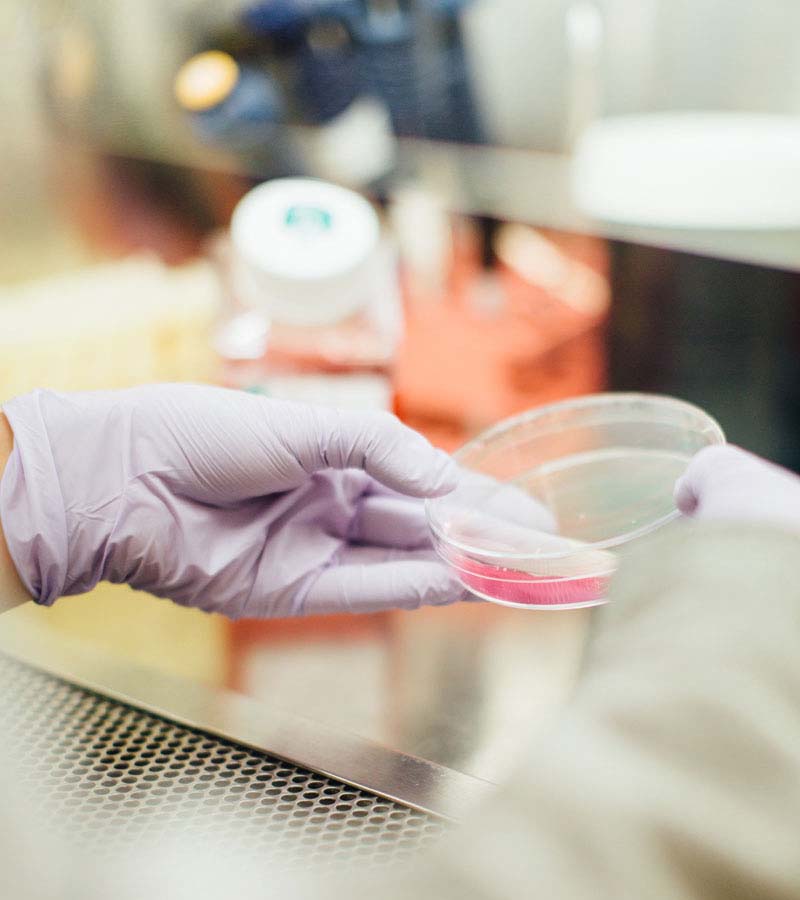

Why choose us over others?
Our Background
We had been developing softwares in this industry for more than 15 years, and had been working for an organization for fixing their problems and generating new software for them. Throughout these years we have been polishing our capabilities.
Additional services
Learn more Watch videoDon’t forget to check the full manual/guide of viplims web and application, and it would be updated with the passage of time if we introduce any new feature that can help you to be more productive.
Learn more
Win prospects over
Turn conversations into conversions. Our sales management tools are designed to enhance productivity and pipeline visibility for sales teams so they can focus on the prospect, not the process.
empower your employees
Learn more Watch video“By giving our sales and support teams everything they need in one platform, they are able to effectively and efficiently collaborate and improve the customer experience.” - Simon Rodrigue, Senior Vice President and Chief Digital Officer
Learn more